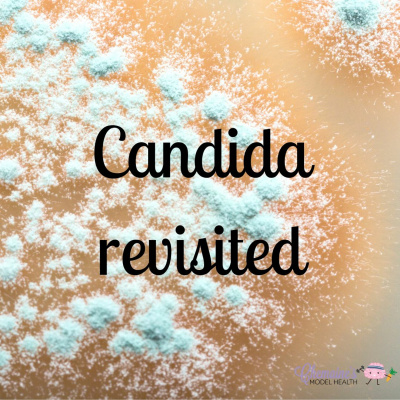
Find Your Model Health!

Find Your Model Health!
#227 Candida Revisited
- Autor: Vários
- Narrador: Vários
- Editor: Podcast
- Duración: 0:30:58
- Mas informaciones
Informações:
Sinopsis
In this episode we are revisiting yeast overgrowth, or Candida. We go in depth on the signs, symptoms, causes, testing and the steps to take on addressing Candida. Please let me know if I can help you at all around this topic. As always, please like share and subscribe if you have not already. :)